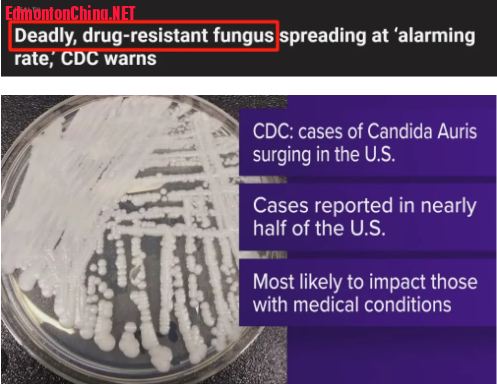

鲜花( 61)  鸡蛋( 0)
|
近日,美国疾病控制与预防中心(CDC)突然发出警告——一种“致命耐药真菌”正在悄然传播!
+ M* K' D- R2 q" n- [7 o% {8 @" V
5 }) g- j4 d0 E& `CDC将耳念珠菌(Candida auris)列为“紧急抗菌耐药威胁”(Urgent Antimicrobial Resistance Threat),对多种抗真菌药物具有高度耐药性,并可在医院环境中长期生存,传播迅速。
% C1 \$ S: h; W9 X- N
+ M7 z2 ^6 _; S) k. v& C1 f
 ! D! p; W) C, z6 G
! D! p; W) C, z6 G
' S; M; W- S: Y y3 r
2009年,这种真菌在日本首次被发现,此后这个病原体就迅速扩散至全球多国,在医院和长期护理机构中引发持续性爆发事件。
/ f7 M8 u5 c* Z2 e3 _
6 C* X& ^: q' _8 D1 } U/ W0 A) Q, y这种真菌也在加拿大现踪,全国首宗病例出现在2012年。截至 2025年3月26日,加拿大公共卫生署已报告 65 例确诊。. {& P# y6 B# b% B
3 g" i7 O ~. }- \/ J
今年1月份,安大略省卫生局正式将耳念珠菌列为“对公共健康有重大意义的疾病”,必须依法上报并加强监测与控制。& m) I; F: X- Y! I/ h' D1 m# C
) E) w$ d8 c2 u7 h微生物学家杰森·泰特罗(Jason Tetro)警告,“这种真菌如果只是在皮肤表面停留,可能毫无危害,但一旦进入血液或黏膜系统,尤其是对免疫系统较弱者来说,可能导致致命感染。”: ~1 K' K- X# R `- Z
! L! J) L" b" l一般来说,耳念珠菌的死亡率可能高达50%至60%。4 ^2 ^3 C6 q; \- `/ {+ B
/ E: ^6 ]# y4 H [ C
( W7 K' b/ C4 Y. r" c* B! |
( W7 K' b/ C4 Y. r" c* B! |
; H9 X, G8 ]' ?9 ]9 d" d4 X) I更令人担忧的是,耳念珠菌不仅可人际传播,还能在门把手、病床栏杆和医疗设备等表面存活数周。
3 j" L8 s$ |0 t/ y1 J& L. E% O) {! e3 r# W. ~. s C
不仅如此,因为具有高耐药性,一般的清洁剂对耳念珠菌都无效,仅有双氧水或漂白剂可有效消毒。' h+ }. Q' f7 b5 z2 S, ^9 z3 w
) V5 h0 c: J- \: [. J3 I研究显示,佛罗里达州医院的耳念珠菌感染从2019年至2023年急剧增加,而且所有检测样本对常用抗真菌药物氟康唑都表现出抗药性。/ B J5 k+ v* E+ z# C* l
! I6 A% p5 ]( X0 ~) x2 |6 T0 }9 ?
不仅仅是耳念珠菌,加拿大公共卫生亮起的是“双重警报”——超级真菌与麻疹疫情双线蔓延! - c2 ~6 K% I0 W- W
9 p) D/ y5 X0 }; p$ l8 D: _% M( T
与此同时,安大略省的麻疹疫情正在快速蔓延!. L* v8 B( V7 ^& k$ T
% o* K5 T! s0 V$ D ^$ l$ |9 ]
最新数据显示,2024年10月以来,已累计572人确诊或疑似感染,仅过去1周就新增102 例。
* ]9 u5 A4 K6 D# w, {$ _3 q9 g; o- W4 _+ m0 a( {% Z* \
目前,安省已经有42人因病住院,其中2人需接受重症监护。
1 o' a q7 P9 }( l2 N. c& W' w
: J9 s* j' g, P现在疫情主要集中在安省西南部和Grand Erie地区,但已迅速扩散至其他地方,一周内病例几乎翻倍。 A! d# m) W; O2 {" L K
( H! n, `' D \$ J5 H; G麻疹是一种极具传染性的病毒性疾病,可在空气中或污染表面上存活长达2小时。
4 j3 l) V8 p8 l# G+ ]! r6 l9 y9 A+ [, y1 p: E l
典型症状包括发烧、咳嗽、流鼻涕、眼红,随后出现红色皮疹,从脸部蔓延至全身。严重情况可能导致肺炎、脑炎,甚至死亡。
4 m0 @8 a3 h( o& g/ K5 Q- b% t3 e4 ^+ Y' B9 q5 K
除了安大略省,加拿大还有阿尔伯塔省、魁北克省和BC出现感染病例。
% h8 U e( U, O8 H
1 x- ]; f; a6 o0 v' Y! f' r; ?面对双重威胁,加拿大各级公共卫生机构已启动应急机制。专家呼吁各省加强医院与长期护理机构内的真菌感染防控措施,并提升公众对麻疹疫苗接种的重视。
6 N# j. g1 @& O8 \
0 D g$ |) G4 }; E, ?加拿大卫生部门正加紧部署应对措施,并呼吁公众保持警觉,特别是有免疫缺陷、患慢性病或未完成麻疹疫苗接种者,应避免进入高风险区域,并关注官方发布的疫情通报。 |
|
